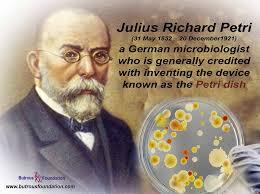
Richard Petri
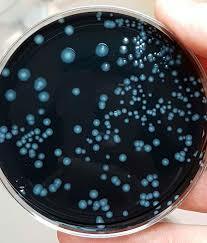
Legionella pneumophila

Historia de la microbiología y su relación con la agricultura by Ana Karen Guerra Córdova.
By karenguirre
-
se encuentra en el período Neolítico, cuando la economía de las sociedades humanas evolucionó desde la recolección, la caza y la pesca a la agricultura y la ganadería.
-
Inventó el primer microscopio de dos lentes con la ayuda de su padre.
-
El procedimiento fue el de poner carne cruda en dos frascos, uno abierto y otro cerrado. Pero en el experimento de Francesco solo aparecerían en el frasco abierto. Y demostró que si se cerraba este frasco en ese momento, las orugas se convertían en moscas.
Luego esas moscas ponían huevos y de esos huevos era de donde salían las larvas. Éstas se convertían en moscas, que a su vez podían poner huevos. Y se reproducía el mismo ciclo. -
Descubrió por primera vez lo que él llamaría "animálculos", y que en realidad hoy sabemos que son protozoos y bacterias. Fue el primero en ver los glóbulos rojos y los espermatozoides.
-
Desarrolló la primera vacuna contra la viruela humana.
-
Descubre un hongo (phytophthora infestans) que produce la podredumbre de la papa.
-
Propuso la utilización de antisépticos para evitar la fiebre puerperal.
-
Demostró que el cólera era producto del consumo de aguas contaminadas con partículas de materia fecal.
-
Este proceso consiste en un tratamiento de dar calor a un producto para matar todas las bacterias patógenas y reducir la actividad enzimática.
-
Descubrió una serie de sustancias ácidas denominadas protamina del esperma de una trucha.
-
Demuestra que el carbunco o ántrax es causado por Bacillus anthracis
-
Inició su investigación sobre el carbunco, una enfermedad que causaba estragos en el ganado lanar.
En este mismo año también desarrolló la vacuna para prevenir la rabia. -
Descubre la Mycobacterium tuberculosis
-
Desarrolló la tinción de gram; haciendo un proceso de coloración a las bacterias y de este modo observó que algunas bacterias se teñían de morado y las denominó gram positivo y las que no se teñían de ningún color las denominó gram negativos.
-
Obtuvo una exitosa efectividad la vacuna contra la rabia, después de que a un niño lo atacó un perro dándole 14 mordidas.
-
descubre la escherichia coli
-
Introdujo el uso de las placas Petri en microbiología.
-
Aísla bacterias fijadoras de nitrógeno de los nódulos presentes en las plantas de leguminosas.
En la agricultura esta bacteria junto con la Azospirillum son utilizadas como biofertilizantes. -
Demuestra que la fiebre de las Montañas Rocosas es transmitida por garrapatas, y aisló el microorganismo causante de la enfermedad (que él llamó rickettsia).
-
Descubre el virus que produce tumores en pollos.
-
Aísla la penicilina de un cultivo de Penicillium notatum.
-
El dr. Minoru Shirota aislo y cultivó la bacteria anaeróbica de origen intestinal y su función en la agricultura es descomponer la materia orgánica y como inoculantes para ensilaje.
-
Desarrolla el microscopio de contraste que permite observar microorganismos vivos.
-
Inventa el microscopio electrónico.
-
Reconocen las archeas como el tercer dominio de los seres vivos.
-
Descubre los priones, agentes causantes de la encefalopatía espongiforme bovina
-
Descubren Epulopiscium fishelsoni, la mayor célula eucariota
-
Aparece la gripe aviar, producida por el subtipo H5N1 del virus A de la influenza.
-
Secuenciación del genoma de Legionella pneumophila, el microorganismo productor de la enfermedad de los legionarios.
-
Esta bacteria puede producir dos esporas en la misma célula madre. y en la agricultura esta es una descomponedora de materia orgánica.
-
La prueba de Ames, también llamada las salmonelas prueba, es un análisis bacteriano a corto plazo usado para determinar las substancias que causan mutaciones de gen.
Plan projects on a visual timeline
Map milestones, phases, deadlines, and key events in one place so the sequence is easier to see and share. Timetoast is a timeline maker for work, school, research, and stories.